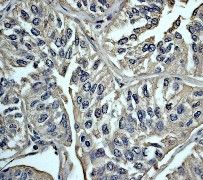

> Antigen, Antibodies, ELISA, Western Blot > Primary Antibody > Monoclonal Antibodies > Calmodulin Antibody (CaM) (C-term)Brand |
Leading Biology | Catalog Number |
APR07083G |
Product Type |
Monoclonal Antibodies | Field of Research |
|
Product Overview |
We constantly strive to ensure we provide our customers with the best antibodies. As a result of this work we offer this antibody in purified format.
We are in the process of updating our datasheets. If you have any questions regarding this update, please feel free to contact our technical support team.
This product is a high quality Calmodulin antibody (CaM) (C-term).
|
||
Molecular Weight |
16838 Da
|
||
Cellular Localization |
Antigen Cellular Localization:
Cytoplasm, cytoskeleton, spindle. Cytoplasm, cytoskeleton, spindle pole. Note=Distributed throughout the cell during interphase, but during mitosis becomes dramatically localized to the spindle poles and the spindle microtubules
|
||
Host |
Rabbit
|
||
Species Reactivity |
Human, Mouse, Rat
|
||
Target |
A synthetic peptide corresponding to residues in the C-terminus of human Calmodulin was used as immunogen.
|
||
Clone |
EP799Y
|
||
Symbol |
CALM, CAM, CAM1
|
||
GeneID |
|||
UniProt ID |
|||
Function |
Calmodulin mediates the control of a large number of enzymes, ion channels, aquaporins and other proteins by Ca(2+). Among the enzymes to be stimulated by the calmodulin-Ca(2+) complex are a number of protein kinases and phosphatases. Together with CCP110 and centrin, is involved in a genetic pathway that regulates the centrosome cycle and progression through cytokinesis.
|
||
Summary |
Calmoduin (CaM) is a calcium modulator protein and a transducer of calcium signals (1-2). Upon calcium binding, calmodulin undergoes conformational changes and binds and modulates a diverse array of proteins. Calcium-bound CaM (Ca2+-CaM) can assume a variety of shapes depending on the target (3). Ca2+-CaM binds many kinases, phosphatases, signaling proteins, and structural proteins affecting a wide variety of processes including neurotransmitter release, muscle contraction, metabolism, apoptosis, inflammation, membrane protein organization, and cytoskeleton movement (2, 4-5).
|
||
Form |
50 mM Tris-Glycine (pH 7.4), 0.15 M NaCl, 40% Glycerol, 0.01% sodium azide and 0.05% BSA. |
||
Storage & Stability |
Store at +4°C short term. For long-term storage, aliquot and store at -20°C or below. Stable for 12 months at -20°C. Avoid repeated freeze-thaw cycles.
|
||
Applications |
WB, IHC
|
||
Dilution |
WB~~1:1000~2000
IHC~~1:250~500
|
||
Synonyms |
Calmodulin, CaM, CALM1, CALM, CAM, CAM1
|
||
Images |

A. Western blot analysis on NIH 3T3 cell lysate using anti-Calmodulin (C-term) RabMAb (Cat. APR07083G), dilution 1:5,000
B. Immunohistochemical analysis of paraffin-embedded human urinary bladder carcinoma using anti-Calmodulin RabMAb (Cat. APR07083G). |
||
Specification |
|||
Quantity |
|
||
| Select | Brand | Catalog No. | Product Name | Pack Size | Type | Field of Research | Specification | Quantity | Price(USD) | |
| 1 | Leading Biology | APG02467G | CCK4 / PTK7 Antibody (clone 4F9) | 50 μl | Monoclonal Antibodies |
|
$495.00 | Add Ask | ||
| 2 | Leading Biology | AMM04683G | GALT Antibody (clone 4C11) | 50 μg | Monoclonal Antibodies |
|
$545.00 | Add Ask | ||
| 3 | Leading Biology | AMM01402G | Vimentin (Mesenchymal Cell Marker) Antibody - With BSA and Azide | 50 ug | Monoclonal Antibodies |
|
$395.00 | Add Ask | ||
| 4 | Leading Biology | APR08280G | LTA4H / LTA4 Antibody (clone 9G8) | 50 μl | Monoclonal Antibodies |
|
$495.00 | Add Ask | ||
| 5 | Leading Biology | AMM00172G | CD1a / HTA1 (Mature Langerhans Cells Marker) Antibody - With BSA and Azide | 50 ug | Monoclonal Antibodies |
|
$395.00 | Add Ask | ||
| 6 | Leading Biology | AMM05750G | CEBPA Antibody | 100 μl | Monoclonal Antibodies |
|
$545.00 | Add Ask |
 Leading Biology Inc.
2600 Hilltop DR, Building G, B Suite C138
Richmond, CA, 94806
Tel: 1-661-524(LBI)-0262
Email: info@leadingbiology.com
Leading Biology Inc.
2600 Hilltop DR, Building G, B Suite C138
Richmond, CA, 94806
Tel: 1-661-524(LBI)-0262
Email: info@leadingbiology.com
Complete this form and click send to ask us a question, request a quote or simply say hello.

You have 0 item in your cart

You have 0 item in your inquiry list
